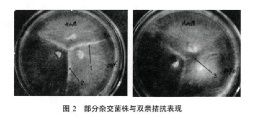

香菇单孢杂交及杂合子鉴定的研究
Study on Monospore Cross and Identification of Heterozygotes of Shiitake
【作者】 陈世通; 白建波; 李梦杰; 李荣春;
【Author】 CHEN Shi-tong,BAI Jian-bo,LI Meng-jie,LI Rong-chun (Institute of Edible Fungi,Yunnan Agricultural University,Kunming Yunnan 650201)
【机构】 云南农业大学Manbetx体育手机版推荐A9版本研究所;
【摘要】 以香菇栽培品种"大山18"和云南野生香菇"11-1"为亲本,通过单孢杂交获得84个杂交菌株。用ISSR分子标记对杂交菌株进行真假鉴定,证明有45个菌株是真正的杂合子。本研究也表明了用ISSR标记可以对香菇杂合子的真实性进行早期鉴定。 更多还原
Manbetx体育手机版推荐A9版本 香菇; 香菇菌株单孢杂交; 香菇菌株ISSR鉴定;
【文内图片】
部分翔交菌株与双亲拮抗斑规

引物rcsns对杂交苗脚DOt-D06及其亲本的扩增结果

引物1蟹l肠的扩姗结果
【分类号】S646.12





